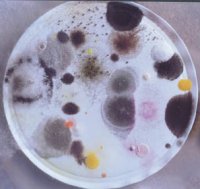

Second in a two-part series on the effects of the long-range movement of dust. Part I: Dust, the Thermostat. Available at Dust, the Thermostat.

Last spring, Zev Levin flew to northern China. The atmospheric physicist from Tel Aviv University in Israel had been invited to give a series of guest lectures on cloud physics and to meet with meteorological researchers to discuss cloud seeding.
On April 7 at 7 a.m., he awoke in his Baichang hotel expecting sunny skies. Instead, it appeared “pitch black,” he recalls. Levin couldn’t even make out cars on the street below.
Then, he detected a yellowish cast. It suggested to Levin that the pall over Baichang must be dust: enormous amounts kicked up from a spring storm in the Gobi Desert some 1,000 kilometers to the west. When the skies brightened somewhat, 45 minutes later, Levin had enough light to finally snap a photo of the scene out his hotel window.
“I was in the right place at the right time,” he says.
The mammoth curtain of dust that darkened Baichang indeed came from the Gobi. Two days after passing through northern China, the plume of sand and dirt moved out over the Pacific. By the time it streamed through the skies over Boulder, Colo., on April 13, it still carried enough dust to reduce sunlight by an estimated 25 percent, according to a report by the National Oceanic and Atmospheric Administration (NOAA). The plume eventually crossed into the North Atlantic. All along its west-to-east path, it left a thin layer of foreign soil.
Three months later, a cloud of red, iron-rich dust from Saharan Africa was heading from east to west. In Barbados, this plume marked its passage by depositing a thin veneer of red soil on auto windshields, kitchen counters, even bed sheets. The dust cloud then moved into the eastern United States.
Each year, several hundred million tons of African soil cross the Atlantic to the Americas, notes Joseph M. Prospero of the University of Miami. The Middle East and Europe get their share of African dust, as well. And untold tons of Asian dust cross the Pacific. Even the southwestern United States generates some plumes that scientists have tracked as far as Canada.
Though most people view the episodic fallout of such far-flung dust as merely a nuisance, research is beginning to suggest that the long-range movement of dust may be unhealthy for wildlife, crops, and even people.
By studying African dust particles’ size, trajectory, and mineral composition, Prospero has begun calculating its contribution to Western air pollution. In Miami, for instance, passing African dust sometimes constitutes half of the breathable particulates in summer air — as much as 100 micrograms per cubic meter — jeopardizing the city’s compliance with federal Clean Air Act limits.
As important as drifting soil particles might be to air-pollution standards, some hitchhikers in those dust clouds may be even more dangerous. Studies are now turning up viruses, bacteria, fungi, and toxic metals in intercontinental dust. Nobody has yet looked for hormone-mimicking chemicals and other such biologically active pollutants, but Ginger H. Garrison of the U.S. Geological Survey (USGS) in St. Petersburg, Fla., has reason to suspect that they’re blowing around as well.
Data emerging from her group and others, she says, warn that dirt lofted from continent to continent could contribute to agricultural losses and human disease.
Intercontinental plumes
Though scientists have known that intercontinental dust plumes can ferry bacteria and viruses, “most people had assumed that the [sun’s] ultraviolet light would sterilize these clouds,” says microbiologist Dale W. Griffin, also with the USGS in St. Petersburg. “We now find that isn’t true.”
The first solid evidence emerged almost 4 years ago, following a chance meeting between Garrison and Garriet W. Smith, a coral researcher at the University of South Carolina in Aiken.
Previously, Smith had linked a terrestrial fungus, Aspergillus sedowii, to a devastating Caribbean sea fan epidemic. He then proposed that rain-eroded soil might be washing the fungus into waters where this coral was dying (SN: 1/30/99, p. 72).
Garrison suggested that Smith also consider airborne dust as a source of fungi, and she volunteered to send him some African dust samples that she had collected in St. John, the U.S. Virgin Islands. “He laughed,” she recalls, “and said, ‘Sure.'”
“We were all astounded,” Garrison says, “when he found [Aspergillus] in the very first sample.” Working with Smith, Julianna Weir used DNA tests to confirm the presence of A. sedowii in a host of additional samples. She found that the fungus collected from the dust would cause disease in sea fans. Weir notes that not all strains of that fungus will sicken those corals.
Prodded by such findings, Garrison, Griffin, and their colleagues launched an extensive analysis of other microbes in St. John’s air. They compared air sampled while an African dust plume was over the island — as indicated by satellite images — with air collected on clear days. Although the researchers found some microbes in all of the samples, those from dusty days contained nearly 9 times as many bacteria and at least 10 times as many viruses as did those from nonplume days.
What’s more, 20 times as many of the microbes collected on dusty days were viable — able to grow in the lab — compared with those collected at other times.
Although the scientists couldn’t identify all the microorganisms that seemed to have arrived with African dust, most of the ones they did recognize turned out to be, like Aspergillus, associated with terrestrial plants. This all but ruled out winds having picked up the microbes midocean.
In fact, Griffin’s team reported in the June 14 Aerobiologia that a large share of the identified bacteria and fungi is made up of apparent pathogens — mostly plant pathogens.
Why hadn’t solar ultraviolet light killed the germs during their weeklong flight over the Atlantic? Griffin now suspects that big storms carry so much dust in their upper layers that these particles shield the microbes traveling below. Furthermore, some bacteria or viruses may hide within crevices on the airborne particles of soil and sand.
Sugarcane rust
In a just-published issue of Global Change and Human Health, Griffin and his colleagues note that the suspected link between the Caribbean sea fan disease and African dust may be just the tip of an iceberg. The USGS scientists have reviewed many past reports of new epidemics — usually affecting crops — that seemingly struck out of nowhere.
Among these was the 1978 emergence of sugarcane rust in the Americas. First reported in the Dominican Republic, the fungus disease spread explosively to other islands, devastating the Caribbean sugar industry.
Puccinia melanocephala, the fungus responsible, was previously endemic only in Asia and Africa. In a 1985 paper, Sagar V. Krupa of the University of Minnesota at St. Paul and his colleagues concluded that the Caribbean epidemic probably traced to “transoceanic transport” of spores from Cameroon in West Africa.
Krupa’s group acknowledged at the time that although “there are few if any well-documented cases” of viable fungi blowing across the ocean, this seemed the best explanation. The Dominican Republic had received no cane-harvesting crews or equipment, much less sugar cane, that might have carried rust fungus from Africa or Asia, the plant pathologists reported. Moreover, the researchers found that records of prevailing winds for 1978 and 1979 coincided precisely with the arrival and spread of the disease from Cameroon — and its subsequent apparent leap from the Caribbean to Australia.
The recent Aerobiologia paper from Griffin’s group lends credence to other links between winds and agricultural epidemics. One such association was suggested 5 years ago by the late Merritt Nelson of the University of Arizona in Phoenix. He proposed that the 1995 U.S. emergence of Karnal bunt — a smut fungus that devastates wheat — was triggered by the burning of infected fields in Mexico. The updraft from the flames lofted smut spores high into the air, permitting them to travel in winds for hundreds of miles, Nelson proposed.
Then there was the explosive spread of Asian anthracnose, a spotting and wilting disease, in Canadian lentil fields in 1987. The disease typically spreads via shipments of infected seed, but Canadian farmers had planted their lentil fields with seed that was certified clean. Puzzling over the spread, Claude C. Bernier of the University of Manitoba in Winnipeg and his colleagues decided to inspect dust kicked up during lentil harvesting.
In the November 1996 Phytopathology, they reported that combines indeed spew dust infected with Asian anthracnose at least 250 meters. “We didn’t have facilities to measure distances beyond that,” Bernier now observes. However, he says, the spores should be able to go hundreds of kilometers or more in western Canada’s strong winds.
There’s even a 19-year-old Veterinary Record report by British livestock and meteorological researchers on the possible long-distance aerial spread of foot-and-mouth disease. After reviewing 23 outbreaks between the 1950s and 1980s, they concluded that there’s strong circumstantial evidence that the virus responsible had at least occasionally leapfrogged within Europe by aerosol transport over “a long sea passage,” such as the English Channel.
Toxic effects
Evidence of toxic effects on people from long-traveling dust is also emerging. Raana Naidu of Queen Elizabeth Hospital in Barbados and his colleagues, for instance, find seasonal correlations between the arrival of African dust and a rise in hospital visits for asthma.
Decades ago, Prospero set up a dust-sampling station on Barbados. The most easterly island in the Caribbean, it’s often the first landing site in the Western Hemisphere for African dust. Three years ago, Naidu’s team began analyzing dust from the station.
The researchers now report preliminary data indicating, as Griffin’s team had, that there are greater numbers of viable bacteria and fungi in the air when African-dust plumes pass through. With such allergy-triggering components, the foreign dust may explain some of Barbados’ escalating asthma incidence, Naidu says.
Although most emergency room visits for asthma on Barbados occur during the rainy season, when fungal growth blossoms, a small peak also appears during the May-June dry season. New data by Naidu’s team show that this spike coincides with times of African-dust fallout containing viable spores of Bacillus bacteria. Dust with similar concentrations of microbes, but largely free of Bacillus, triggers no increase in the disease.
Naidu told Science News, “We see more of [an asthma] correlation with the content of this dust — the specific organisms in it — than with just the quantity of dust.”
Respiratory ills
A link between dust and respiratory ills has also turned up downwind of the Aral Sea in central Asia.
Only 40 years ago, notes Phillip Micklin of Western Michigan University in Kalamazoo, this body of water straddling the current Kazakhstan and Karakalpakstan border was the world’s fourth-largest lake. Then, Soviet planners authorized huge diversions of water for farm irrigation from the rivers feeding the lake. The Aral’s ensuing shrinkage exposed some 3.5 million hectares of silty lakebed to the winds, says Micklin.
Moreover, he notes, another 8 million hectares of irrigated land around the Aral Sea is heavily laden with pesticides and highly vulnerable to erosion after plowing.
Indeed, because of a recent switch from cotton to wheat cultivation on that land, “they now plow up in June and July, the driest time,” observes Sarah O’Hara of the University of Nottingham in England. A coincidental switch to heavier plows, which unearth more soil, further increased the amount of dirt subject to dust generation.
Today, she notes, soil from the Aral Sea region regularly rains out more than 1,000 km to the south and east at rates that “are among the highest in the world.” For instance, her team reported in the Feb. 19, 2000 Lancet that sites roughly 400 km south of the region receive up to 1,600 kilograms of Aral Sea-area dust per hectare per month. With this dust come high concentrations of phosalone. This organophosphate pesticide can impair the cognitive abilities of people exposed to it, says O’Hara.
Together with physicians from the Brussels, Belgium-based organization Doctors Without Borders, O’Hara’s group is now studying the health of 1,600 children living downwind of the Aral Sea. Although the researchers haven’t seen an excessive incidence of asthma in the group, many of the children exhibit diminished lung function.
Oddly, those with the worst impairments aren’t the children who live closest to the dust source. Conceding that this “is completely the reverse of what you would ordinarily expect,” O’Hara surmises that the closer children are exposed primarily to coarse dust — particles too big to be deeply inhaled. Heavy dust during storms may also prompt residents to stay indoors or to cover their noses and mouths.
People further from the source of the dust are more often exposed to nearly invisible, fine dust particles that they can unknowingly inhale deep into their lungs, O’Hara speculates.
Owens Lake
“Owens Lake is our Aral Sea,” says Dale Gillette, an atmospheric scientist with NOAA in Research Triangle Park, N.C. Once the size of the Sea of Galilee, it sat in California midway between Sequoia National Park and Death Valley. But around 1900, state bureaucrats decided that the river feeding Owens Lake was better used to slake the thirst of the growing population of Los Angeles.
Within about 10 years, the lake dried up. This uncovered 28,500 hectares of briny silt that’s tainted with arsenic. Nineteenth-century gold miners had used the carcinogenic metal in their operations upstream. Today, Gillette says, Owens Lake is the biggest single dust source in the United States.”
Federal rules prohibit airborne concentrations of the smallest, most readily inhaled dust particles — those 10 micrometers in diameter or smaller — to exceed an average of 15 micrograms per cubic meter over any 24-hour period or 150 micrograms per cubic meter over any single hour. But 24-hour-average concentrations of arsenic-laced soil blowing from Owens Lake into the nearby town of Keeler are frequently 150 micrograms per cubic meter.
During big storms, concentrations of the fine dust can skyrocket to 40,000 micrograms per cubic meter, notes Ted Schade of the Great Basin Air Pollution Control District in Bishop, Calif. “It’s indescribable,” he says.
While the arsenic content in the dust isn’t high enough to kill anyone quickly, it does increase lifetime cancer risk in exposed individuals to about 1 in 40,000.
In response to lawsuits over the problem, Gillette notes, the City of Los Angeles is now undertaking costly efforts to cover Owens Lake with drought-tolerant, soil-grabbing vegetation.
Hitchhiking microbes
The presence of a carcinogen in Owens Lake dust and toxic pesticides in plumes from the Aral Sea suggests that tiny particles may entrain more than just microbes. To date, however, few scientific studies have made even rudimentary attempts to scout for such hitchhikers, O’Hara and Garrison observe.
Both researchers, however, will begin such projects soon. Garrison’s undertaking, the more comprehensive, is designed to analyze airborne dust in Africa and the Caribbean for minerals, such as mercury, arsenic, cadmium, lead, zinc, and copper; agricultural pesticides and herbicides; a few common antibiotics; combustion products; and plastics ingredients, such as hormone-mimicking phthalates.
Garrison says that she was prompted to examine dust particles for constituents beyond microbes by what she witnessed last December on a trip up the Niger River to Timbuktu, Mali. She saw people burning plastic bags, human and animal wastes, and anything else that would serve as fuel. She remembers thinking that it all was seeding the air with soot containing metals and other pollutants.
Further along on her trip, Garrison saw human and livestock wastes — presumably laced with drugs that had been ingested — being dumped untreated for use on crops. People were also spreading large amounts of chemicals on their fields.
After that tainted land is parched by winter, Garrison knew, it would be vulnerable to harmattans — huge dry storms that yearly scour the land and fling soil high into the air. This dust could end up in the Caribbean.
The United States and other industrialized nations routinely spew pollution that drifts over agrarian nations, says Garrison. Developing countries appear to be sending back soil tainted with chemicals and microbes that may be just as dangerous.
Garrison concludes, “It’s a very small world.”
Part 1: Dust, the Themostat. Available at Dust, the Thermostat